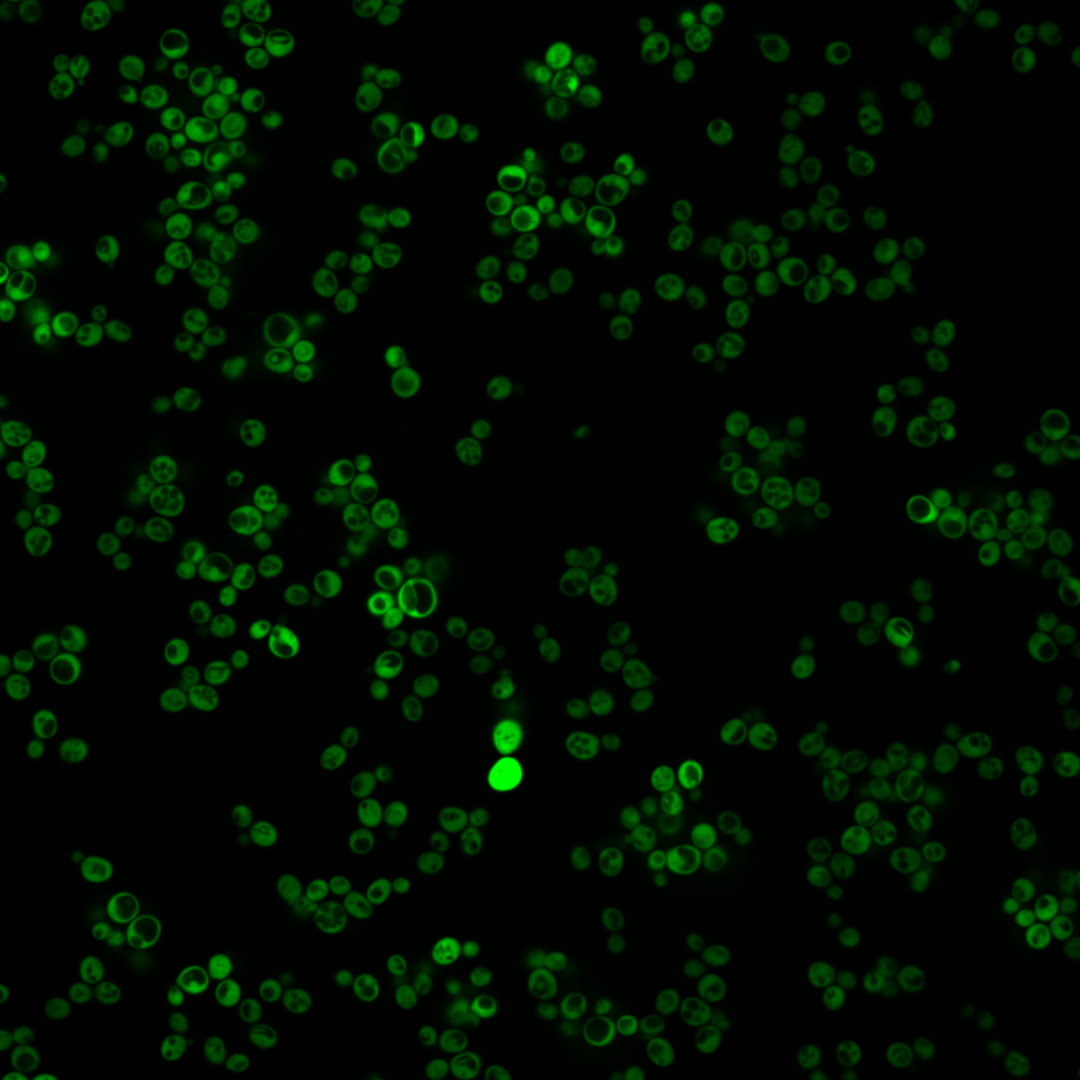
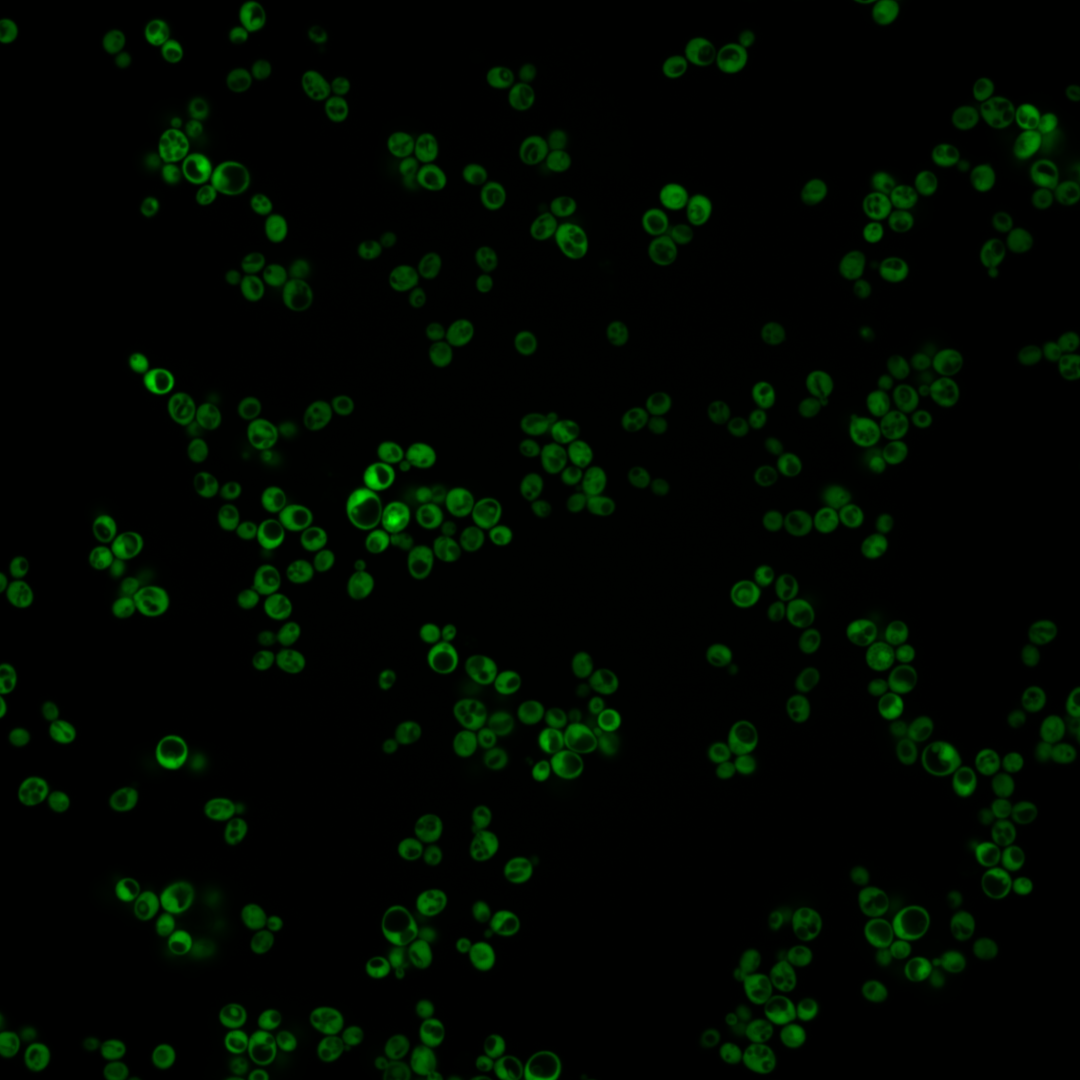
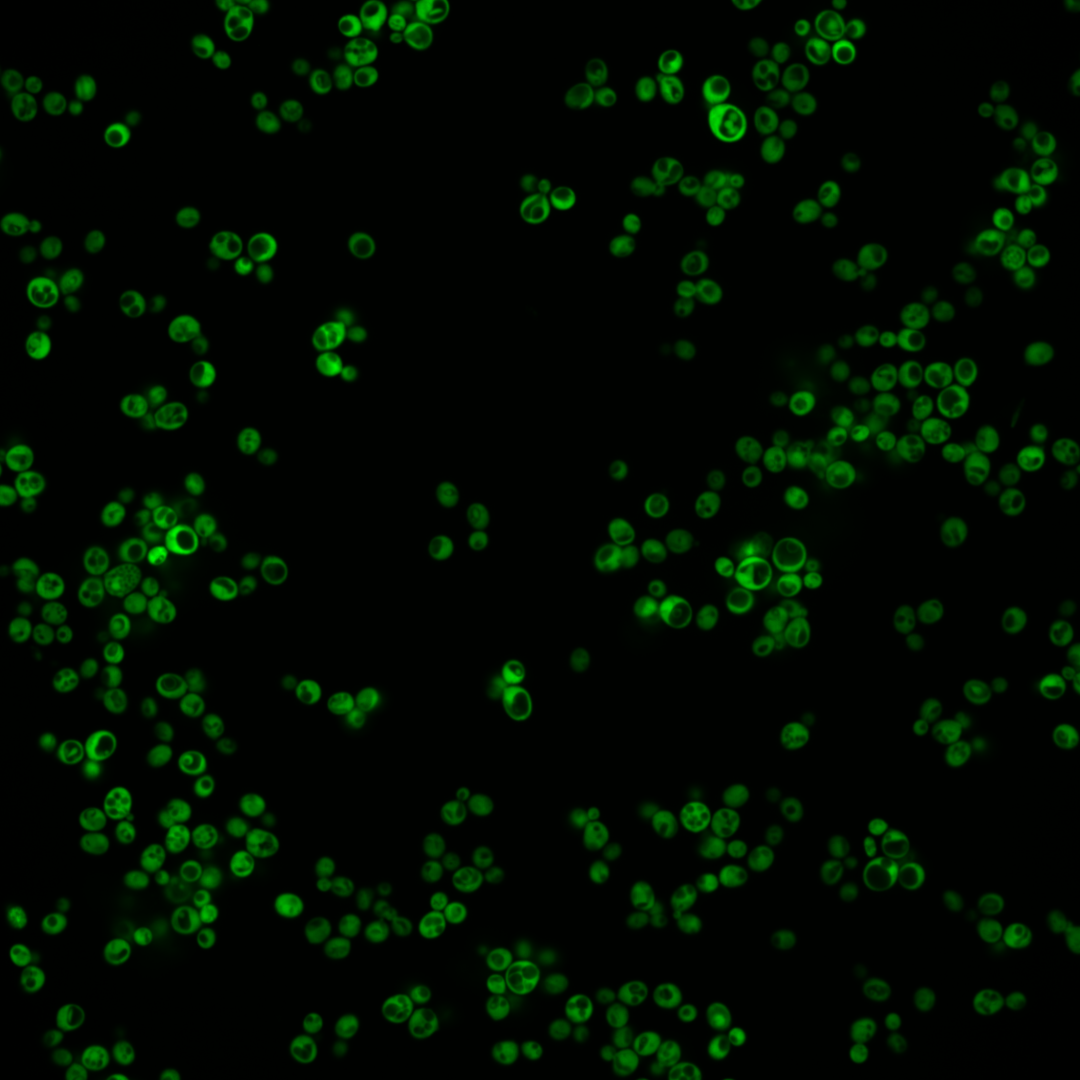
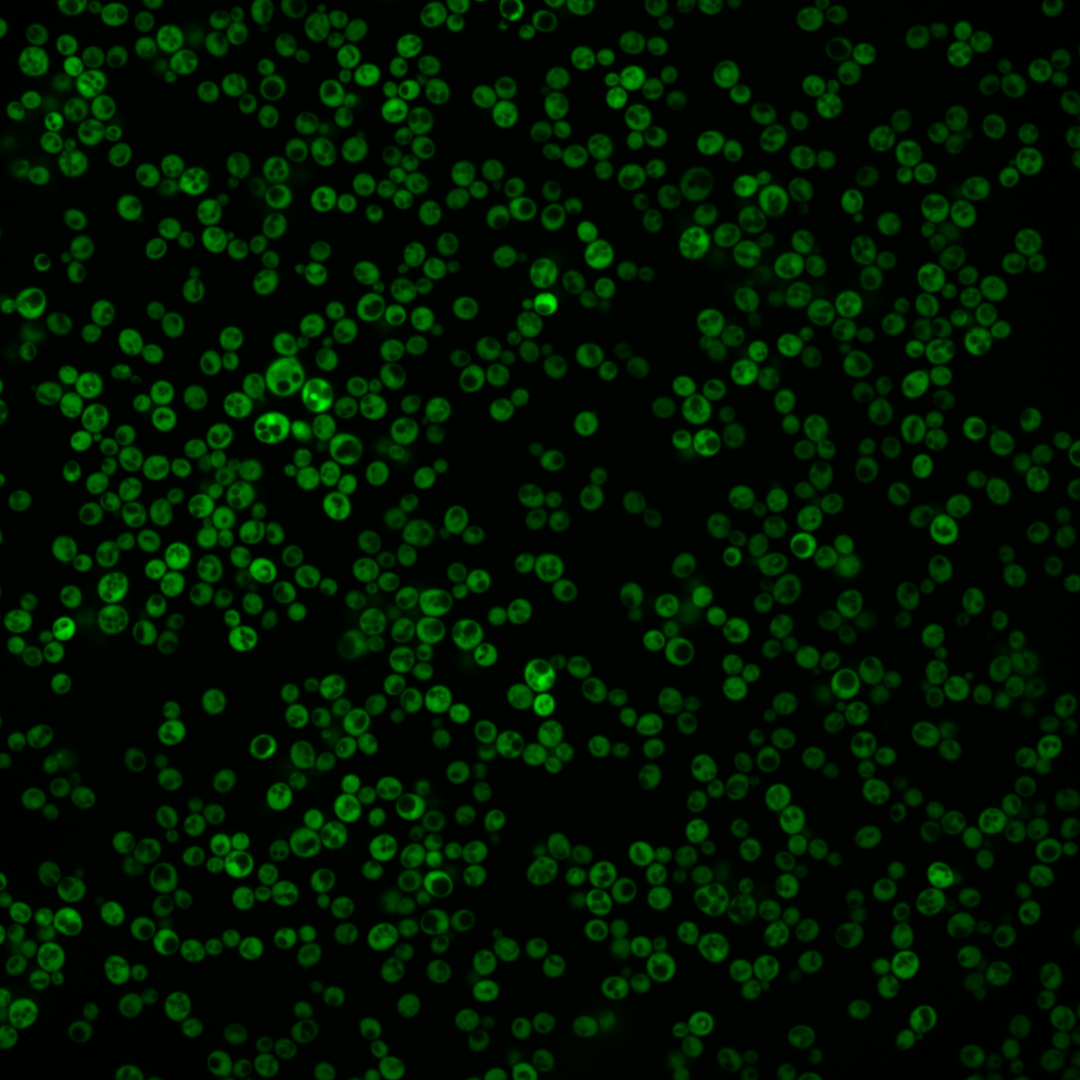
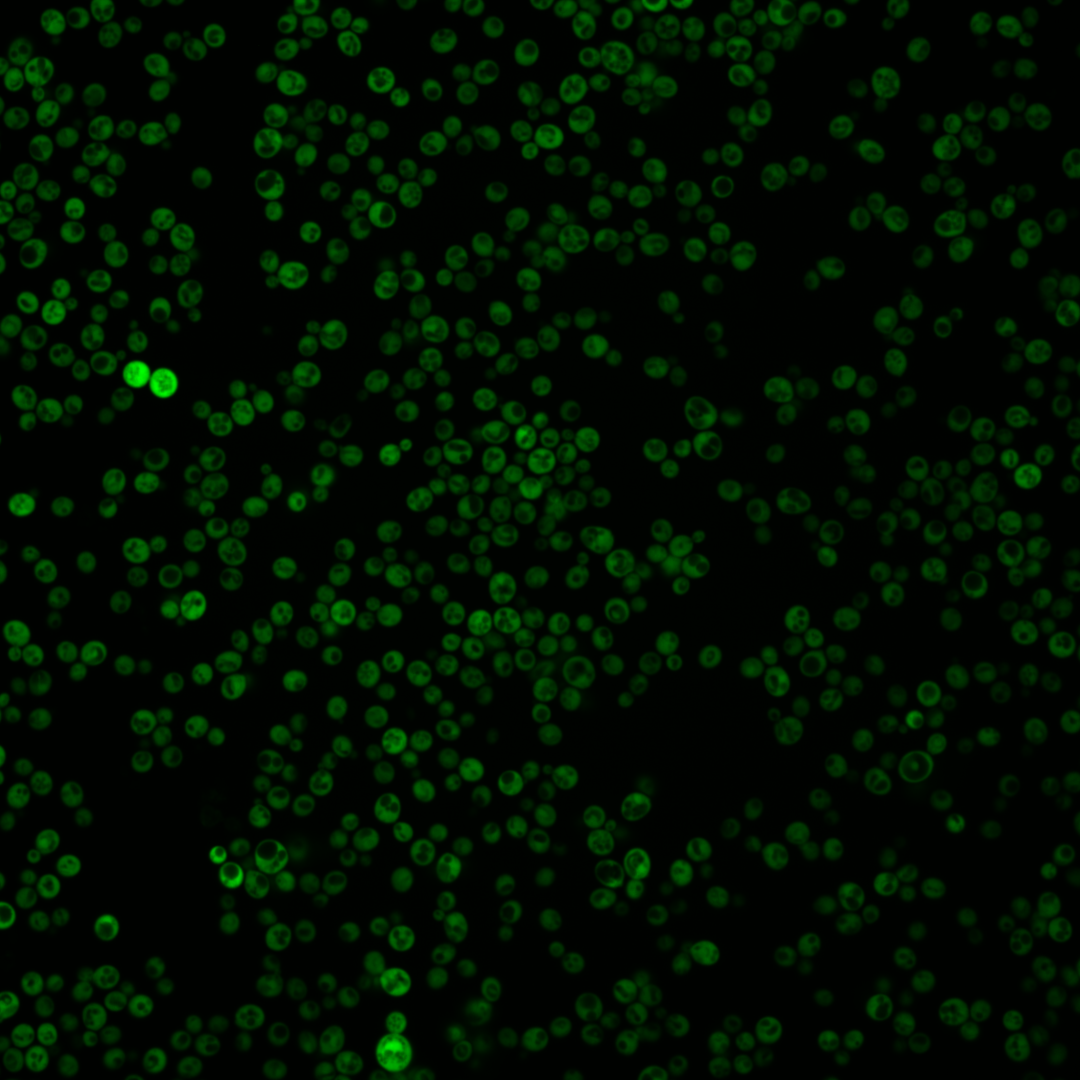
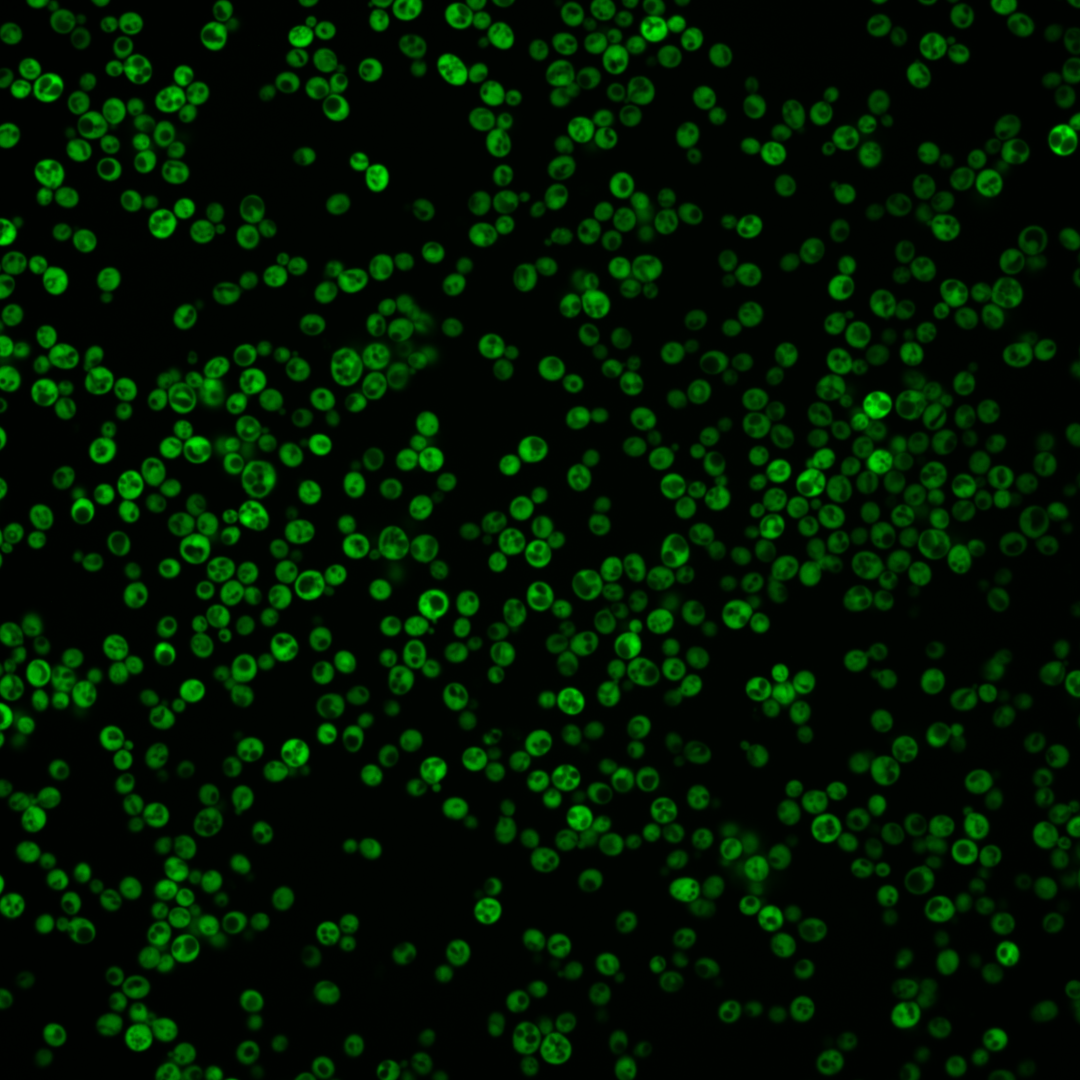
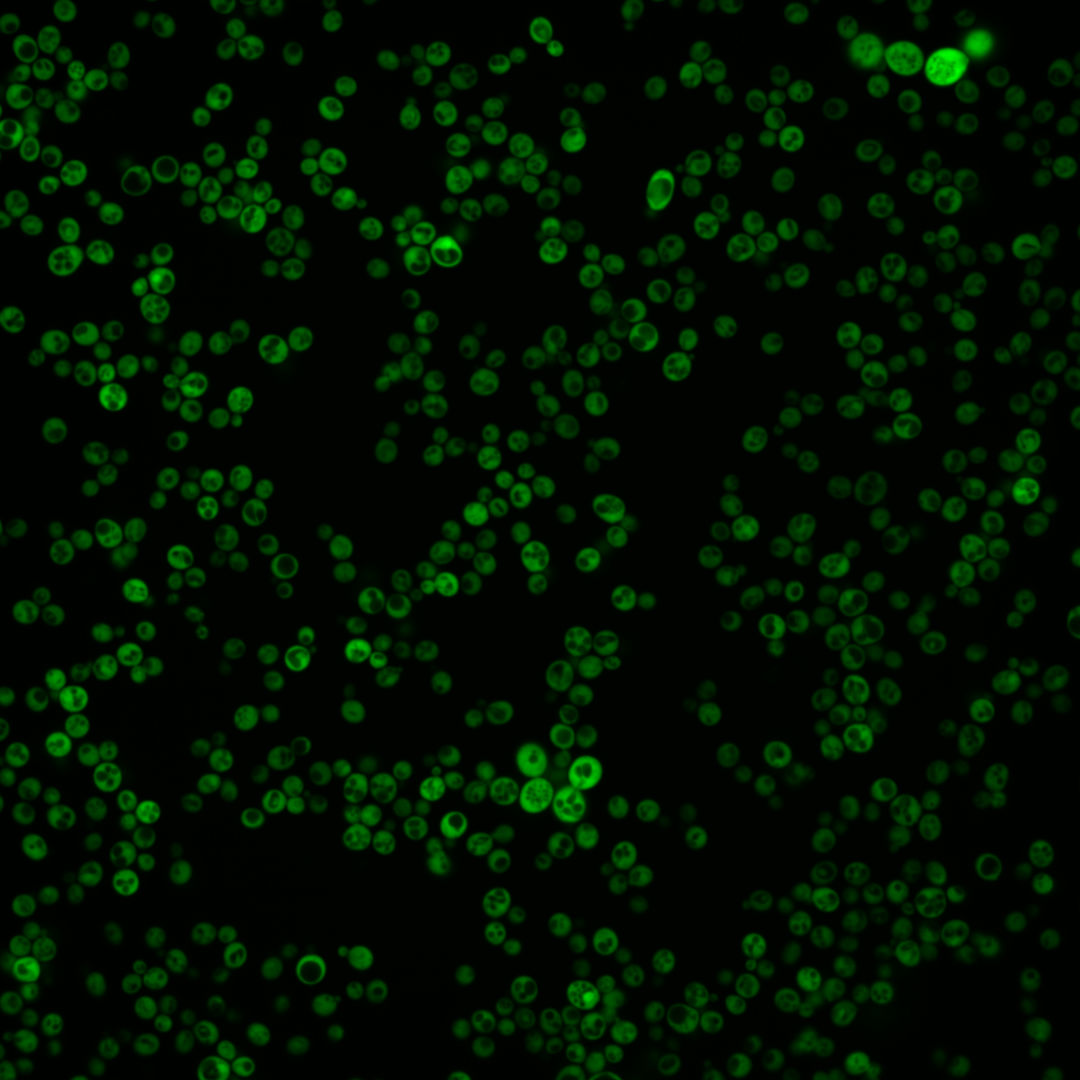

| Standard name | |
|---|---|
| Human Ortholog | |
| Description | Hsp90 chaperone; redundant in function with Hsc82p; required for pheromone signaling, negative regulation of Hsf1p; docks with Tom70p for mitochondrial preprotein delivery; promotes telomerase DNA binding, nucleotide addition; protein abundance increases in response to DNA replication stress; contains two acid-rich unstructured regions that promote solubility of chaperone-substrate complexes; HSP82 has a paralog, HSC82, that arose from the whole genome duplication |
Micrographs




















































































Sub-cellular Localization
Yeast GFP Assignment
Protein Abundance
Localization Change
External localization resources
| ensLOC | DeepLoc | |||||||||||||||||||||||
|---|---|---|---|---|---|---|---|---|---|---|---|---|---|---|---|---|---|---|---|---|---|---|---|---|
| Localization | WT1 | WT2 | WT3 | RAP60 | RAP140 | RAP220 | RAP300 | RAP380 | RAP460 | RAP540 | RAP620 | RAP700 | HU80 | HU120 | HU160 | rpd3Δ_1 | rpd3Δ_2 | rpd3Δ_3 | WT1 | WT2 | WT3 | AF100 | AF140 | AF180 |
| Cortical Patches | 0 | 0 | 0 | 0 | 0 | 0 | 0 | 0 | 1 | – | 0 | 0 | 0 | 0 | 0 | 0 | 0 | 0 | 0 | 0 | 0 | 0 | 0 | 0 |
| Bud | 0 | 1 | 4 | 2 | 10 | 4 | 6 | 7 | 5 | – | 16 | 6 | 0 | 0 | 0 | 1 | 1 | 0 | 2 | 3 | 2 | 0 | 0 | 2 |
| Bud Neck | 0 | 0 | 0 | 0 | 0 | 0 | 0 | 0 | 0 | – | 0 | 0 | 0 | 0 | 0 | 0 | 0 | 0 | 0 | 0 | 0 | 0 | 0 | 0 |
| Bud Site | 0 | 0 | 0 | 0 | 0 | 0 | 0 | 0 | 0 | – | 0 | 0 | 0 | 0 | 0 | 0 | 0 | 0 | – | – | – | – | – | – |
| Cell Periphery | 4 | 4 | 10 | 4 | 14 | 15 | 12 | 13 | 6 | – | 11 | 7 | 0 | 0 | 0 | 9 | 10 | 1 | 0 | 1 | 0 | 0 | 0 | 0 |
| Cytoplasm | 394 | 326 | 456 | 236 | 349 | 480 | 450 | 363 | 334 | – | 323 | 259 | 138 | 155 | 144 | 89 | 68 | 41 | 382 | 316 | 460 | 40 | 111 | 138 |
| Endoplasmic Reticulum | 0 | 1 | 0 | 2 | 17 | 14 | 51 | 63 | 31 | – | 77 | 40 | 0 | 0 | 0 | 3 | 4 | 3 | 0 | 1 | 2 | 0 | 2 | 5 |
| Endosome | 0 | 0 | 0 | 0 | 0 | 0 | 0 | 0 | 0 | – | 0 | 0 | 0 | 1 | 0 | 0 | 0 | 0 | 0 | 0 | 0 | 0 | 0 | 0 |
| Golgi | 0 | 0 | 0 | 0 | 0 | 0 | 0 | 0 | 1 | – | 0 | 1 | 0 | 0 | 0 | 0 | 0 | 0 | 0 | 0 | 0 | 0 | 0 | 1 |
| Mitochondria | 0 | 0 | 0 | 0 | 0 | 0 | 0 | 0 | 0 | – | 0 | 0 | 0 | 0 | 0 | 0 | 0 | 0 | 0 | 0 | 0 | 0 | 0 | 1 |
| Nucleus | 0 | 0 | 0 | 0 | 0 | 0 | 0 | 0 | 2 | – | 1 | 0 | 1 | 0 | 0 | 0 | 0 | 0 | 1 | 4 | 1 | 0 | 0 | 2 |
| Nuclear Periphery | 0 | 0 | 0 | 0 | 0 | 0 | 0 | 0 | 0 | – | 0 | 0 | 0 | 0 | 0 | 0 | 0 | 0 | 0 | 0 | 2 | 0 | 0 | 0 |
| Nucleolus | 0 | 0 | 0 | 0 | 0 | 0 | 0 | 4 | 1 | – | 5 | 4 | 0 | 1 | 0 | 0 | 0 | 0 | 0 | 0 | 0 | 0 | 0 | 0 |
| Peroxisomes | 0 | 0 | 0 | 0 | 0 | 0 | 0 | 0 | 0 | – | 0 | 0 | 0 | 0 | 0 | 0 | 0 | 0 | 0 | 0 | 0 | 0 | 0 | 0 |
| SpindlePole | 0 | 0 | 0 | 0 | 0 | 0 | 0 | 0 | 0 | – | 0 | 0 | 0 | 0 | 0 | 0 | 0 | 0 | 0 | 0 | 0 | 0 | 0 | 0 |
| Vac/Vac Membrane | 0 | 0 | 2 | 2 | 0 | 0 | 0 | 1 | 0 | – | 2 | 3 | 0 | 0 | 0 | 0 | 0 | 0 | 0 | 4 | 2 | 0 | 6 | 2 |
| Unique Cell Count | 394 | 327 | 458 | 241 | 375 | 504 | 510 | 444 | 377 | 422 | 313 | 139 | 157 | 144 | 94 | 72 | 41 | 389 | 338 | 475 | 44 | 125 | 163 | |
| Labelled Cell Count | 398 | 332 | 472 | 246 | 390 | 513 | 519 | 451 | 381 | 435 | 320 | 139 | 157 | 144 | 102 | 83 | 45 | 389 | 338 | 475 | 44 | 125 | 163 | |
Yeast GFP Assignment
Protein Abundance
| Screen | WT1 | WT2 | WT3 | RAP60 | RAP140 | RAP220 | RAP300 | RAP380 | RAP460 | RAP540 | RAP620 | RAP700 | HU80 | HU120 | HU160 | rpd3Δ_1 | rpd3Δ_2 | rpd3Δ_3 | AF100 | AF140 | AF180 |
|---|---|---|---|---|---|---|---|---|---|---|---|---|---|---|---|---|---|---|---|---|---|
| Mean Cell GFP Intensity (1e-4) | 144.5 | 133.0 | 135.2 | 108.9 | 144.7 | 146.5 | 151.9 | 152.7 | 143.2 | – | 132.7 | 145.7 | 133.8 | 182.5 | 203.9 | 404.3 | 415.6 | 361.0 | – | 171.1 | 252.7 |
| Std Deviation (1e-4) | 48.9 | 53.6 | 50.8 | 51.0 | 48.5 | 41.8 | 46.1 | 49.9 | 50.3 | – | 46.2 | 53.3 | 44.8 | 58.4 | 64.5 | 159.3 | 135.0 | 165.8 | – | 57.1 | 108.9 |
| Intensity Change (Log2) | – | – | – | -0.31 | 0.1 | 0.12 | 0.17 | 0.18 | 0.08 | – | -0.03 | 0.11 | -0.01 | 0.43 | 0.59 | 1.58 | 1.62 | 1.42 | – | 0.34 | 0.9 |
Localization Change
| Localization | RAP60 | RAP140 | RAP220 | RAP300 | RAP380 | RAP460 | RAP540 | RAP620 | RAP700 | HU80 | HU120 | HU160 | rpd3Δ_1 | rpd3Δ_2 | rpd3Δ_3 |
|---|---|---|---|---|---|---|---|---|---|---|---|---|---|---|---|
| Cortical Patches | 0 | 0 | 0 | 0 | 0 | 0 | – | 0 | 0 | 0 | 0 | 0 | 0 | 0 | 0 |
| Bud | 0 | 2.0 | 0 | 0 | 1.0 | 0 | – | 2.9 | 0 | 0 | 0 | 0 | 0 | 0 | 0 |
| Bud Neck | 0 | 0 | 0 | 0 | 0 | 0 | – | 0 | 0 | 0 | 0 | 0 | 0 | 0 | 0 |
| Bud Site | 0 | 0 | 0 | 0 | 0 | 0 | – | 0 | 0 | 0 | 0 | 0 | 0 | 0 | 0 |
| Cell Periphery | 0 | 1.3 | 0.8 | 0.2 | 0.7 | -0.6 | – | 0.4 | 0 | 0 | 0 | 0 | 0 | 0 | 0 |
| Cytoplasm | -2.1 | -5.2 | -4.1 | -7.2 | -9.2 | -7.0 | – | -10.7 | -8.8 | -0.4 | -1.1 | 0.8 | -3.9 | -3.8 | 0.4 |
| Endoplasmic Reticulum | 0 | 4.6 | 3.6 | 7.0 | 8.4 | 6.3 | – | 9.6 | 7.9 | 0 | 0 | 0 | 0 | 0 | 0 |
| Endosome | 0 | 0 | 0 | 0 | 0 | 0 | – | 0 | 0 | 0 | 0 | 0 | 0 | 0 | 0 |
| Golgi | 0 | 0 | 0 | 0 | 0 | 0 | – | 0 | 0 | 0 | 0 | 0 | 0 | 0 | 0 |
| Mitochondria | 0 | 0 | 0 | 0 | 0 | 0 | – | 0 | 0 | 0 | 0 | 0 | 0 | 0 | 0 |
| Nucleus | 0 | 0 | 0 | 0 | 0 | 0 | – | 0 | 0 | 0 | 0 | 0 | 0 | 0 | 0 |
| Nuclear Periphery | 0 | 0 | 0 | 0 | 0 | 0 | – | 0 | 0 | 0 | 0 | 0 | 0 | 0 | 0 |
| Nucleolus | 0 | 0 | 0 | 0 | 0 | 0 | – | 0 | 0 | 0 | 0 | 0 | 0 | 0 | 0 |
| Peroxisomes | 0 | 0 | 0 | 0 | 0 | 0 | – | 0 | 0 | 0 | 0 | 0 | 0 | 0 | 0 |
| SpindlePole | 0 | 0 | 0 | 0 | 0 | 0 | – | 0 | 0 | 0 | 0 | 0 | 0 | 0 | 0 |
| Vacuole | 0 | 0 | 0 | 0 | 0 | 0 | – | 0 | 0 | 0 | 0 | 0 | 0 | 0 | 0 |
External localization resources
Images






























Protein Concentration and Protein Localization Data
| R1 | R2 | R3 | ||||||||||||||||
|---|---|---|---|---|---|---|---|---|---|---|---|---|---|---|---|---|---|---|
| G1 Pre-START | G1 Post-START | S/G2 | Metaphase | Anaphase | Telophase | G1 Pre-START | G1 Post-START | S/G2 | Metaphase | Anaphase | Telophase | G1 Pre-START | G1 Post-START | S/G2 | Metaphase | Anaphase | Telophase | |
| Concentration | 56.1238 | 88.976 | 72.9336 | 61.6881 | 72.6916 | 69.1789 | 77.0377 | 111.1848 | 101.1799 | 86.8495 | 76.2118 | 107.871 | 71.6126 | 103.5199 | 86.5988 | 88.3481 | 75.4265 | 91.4043 |
| Actin | 0.0122 | 0.0003 | 0.0001 | 0.0001 | 0.0023 | 0.0085 | 0.0043 | 0.0002 | 0.0009 | 0.001 | 0.0053 | 0.0001 | 0.0055 | 0.0001 | 0.0004 | 0.0001 | 0.0045 | 0.0092 |
| Bud | 0.0019 | 0.0031 | 0.0005 | 0.0002 | 0.0006 | 0.0005 | 0.0007 | 0 | 0.0002 | 0.0001 | 0.0028 | 0.0001 | 0.0005 | 0.0001 | 0.0006 | 0.0002 | 0.0009 | 0.0001 |
| Bud Neck | 0.0008 | 0.0001 | 0.0003 | 0.0003 | 0.0008 | 0.0007 | 0.0004 | 0.0001 | 0.0001 | 0.0002 | 0.0004 | 0.0008 | 0.0002 | 0.0001 | 0.0001 | 0.0002 | 0.0005 | 0.0003 |
| Bud Periphery | 0.0017 | 0.0005 | 0.0003 | 0.0001 | 0.002 | 0.0005 | 0.0004 | 0 | 0.0002 | 0.0001 | 0.0035 | 0.0001 | 0.0004 | 0 | 0.0006 | 0.0001 | 0.0006 | 0.0001 |
| Bud Site | 0.0021 | 0.0002 | 0.0003 | 0.0001 | 0.0018 | 0.0003 | 0.0009 | 0.0002 | 0.0001 | 0.0002 | 0.0025 | 0.0001 | 0.0005 | 0.0001 | 0.0001 | 0.0004 | 0.0009 | 0 |
| Cell Periphery | 0.0014 | 0.0001 | 0.0002 | 0.0004 | 0.003 | 0.0001 | 0.001 | 0.0001 | 0.0012 | 0.0002 | 0.0029 | 0.0002 | 0.0006 | 0.0001 | 0.0003 | 0.0003 | 0.0006 | 0 |
| Cytoplasm | 0.845 | 0.9912 | 0.9779 | 0.9375 | 0.9197 | 0.9157 | 0.94 | 0.9918 | 0.9826 | 0.925 | 0.8404 | 0.9826 | 0.9312 | 0.9896 | 0.961 | 0.9674 | 0.8602 | 0.9777 |
| Cytoplasmic Foci | 0.0176 | 0.0004 | 0.0046 | 0.0093 | 0.0128 | 0.0112 | 0.009 | 0.0022 | 0.0003 | 0.0162 | 0.0112 | 0.0036 | 0.009 | 0.0003 | 0.0076 | 0.0076 | 0.0219 | 0.0005 |
| Eisosomes | 0.0002 | 0 | 0 | 0 | 0.0002 | 0.0001 | 0.0001 | 0.0001 | 0.0003 | 0.0002 | 0.0013 | 0 | 0.0001 | 0 | 0 | 0 | 0.0006 | 0 |
| Endoplasmic Reticulum | 0.003 | 0.0002 | 0.0003 | 0.0017 | 0.0089 | 0.0017 | 0.0015 | 0.0002 | 0.0005 | 0.0005 | 0.0038 | 0.0005 | 0.0019 | 0.0002 | 0.0006 | 0.0004 | 0.0012 | 0.0006 |
| Endosome | 0.0175 | 0 | 0.0003 | 0.0024 | 0.0033 | 0.0082 | 0.005 | 0.0001 | 0.0002 | 0.0024 | 0.0064 | 0.0004 | 0.004 | 0 | 0.001 | 0.0009 | 0.012 | 0.0009 |
| Golgi | 0.0057 | 0 | 0.0001 | 0.0001 | 0.0007 | 0.0021 | 0.0017 | 0.0001 | 0.0003 | 0.0006 | 0.0013 | 0 | 0.0014 | 0 | 0.0004 | 0.0001 | 0.0015 | 0.0008 |
| Lipid Particles | 0.0095 | 0 | 0.0009 | 0.0012 | 0.0059 | 0.0027 | 0.0035 | 0.0014 | 0.0015 | 0.0064 | 0.0052 | 0.0006 | 0.0058 | 0 | 0.0085 | 0.0015 | 0.0059 | 0.0001 |
| Mitochondria | 0.0081 | 0.0003 | 0.0018 | 0.0013 | 0.0021 | 0.0058 | 0.0064 | 0.0007 | 0.0062 | 0.0021 | 0.0371 | 0.0003 | 0.0043 | 0.0006 | 0.0032 | 0.0027 | 0.0328 | 0.0002 |
| None | 0.0124 | 0.0003 | 0.0012 | 0.0162 | 0.0091 | 0.004 | 0.0041 | 0.0003 | 0.0004 | 0.0128 | 0.0186 | 0.0008 | 0.005 | 0.0002 | 0.0037 | 0.006 | 0.0186 | 0.0004 |
| Nuclear Periphery | 0.0092 | 0.0005 | 0.0007 | 0.0043 | 0.0056 | 0.0109 | 0.0029 | 0.0005 | 0.0007 | 0.0028 | 0.0079 | 0.0009 | 0.0054 | 0.0012 | 0.001 | 0.0007 | 0.0024 | 0.004 |
| Nucleolus | 0.0071 | 0 | 0.004 | 0.0023 | 0.0024 | 0.0009 | 0.0017 | 0.0002 | 0.0001 | 0.0073 | 0.011 | 0.0022 | 0.0042 | 0.0042 | 0.0015 | 0.0029 | 0.0049 | 0 |
| Nucleus | 0.0165 | 0.0015 | 0.0023 | 0.004 | 0.0051 | 0.0071 | 0.0052 | 0.0011 | 0.0014 | 0.0039 | 0.0087 | 0.0035 | 0.008 | 0.0027 | 0.0018 | 0.0027 | 0.0065 | 0.0037 |
| Peroxisomes | 0.0054 | 0 | 0.0002 | 0.0001 | 0.0005 | 0.0011 | 0.0008 | 0.0002 | 0.0001 | 0.0071 | 0.0018 | 0.0001 | 0.0043 | 0 | 0.0041 | 0.0004 | 0.003 | 0 |
| Punctate Nuclear | 0.0021 | 0 | 0.0004 | 0.0014 | 0.0019 | 0.0027 | 0.0012 | 0.0001 | 0 | 0.0078 | 0.0007 | 0.0005 | 0.0015 | 0.0001 | 0.0003 | 0.0006 | 0.0038 | 0.0006 |
| Vacuole | 0.0151 | 0.0007 | 0.0024 | 0.0119 | 0.0093 | 0.0104 | 0.0072 | 0.0003 | 0.0016 | 0.0015 | 0.0171 | 0.002 | 0.0044 | 0.0002 | 0.0023 | 0.0032 | 0.0127 | 0.0003 |
| Vacuole Periphery | 0.0055 | 0.0002 | 0.001 | 0.0049 | 0.0022 | 0.0047 | 0.0019 | 0.0001 | 0.0009 | 0.0016 | 0.0099 | 0.0006 | 0.0018 | 0.0001 | 0.0009 | 0.0015 | 0.0039 | 0.0002 |
Sequencing Data
| R1 | R2 | |||||||||
|---|---|---|---|---|---|---|---|---|---|---|
| G1 Post-START | S/G2 | Metaphase | Anaphase | Telophase | G1 Post-START | S/G2 | Metaphase | Anaphase | Telophase | |
| Gene Expression | 372.9818 | 602.4767 | 633.6553 | 502.567 | 529.2593 | 507.9063 | 615.0164 | 675.0226 | 833.4645 | 461.4782 |
| Translational Efficiency | 1.4463 | 1.6276 | 1.2102 | 2.1699 | 1.5838 | 1.0934 | 1.4781 | 1.7678 | 1.3955 | 1.5657 |
Hit Data
| Dataset | Hit |
|---|---|
| Protein Concentration | ✘ |
| Protein Localization | ✔ |
| Gene Expression | ✘ |
| Translational Efficiency | ✘ |
Endocytosis
| Temp | Actin Patch (Sac6-tdTomato) | Cortical Patch (Sla1-GFP) | Late Endosome (Snf7-GFP) | Vacuole (Vph1-GFP) |
|---|---|---|---|---|
| 37℃ | ||||
| RT |
Cell Cycle Omics
CYCLoPs (Hsp82-GFP)
| Gene / Allele | Actin Patch (Sac6-tdTomato) | Cortical Patch (Sla1-GFP) | Late Endosome (Snf7-GFP) | Vacuole (Sac6-tdTomato) |
|---|
| Gene | Images |
|---|
| Gene | Images |
|---|
Images are not yet available
Images are not yet available